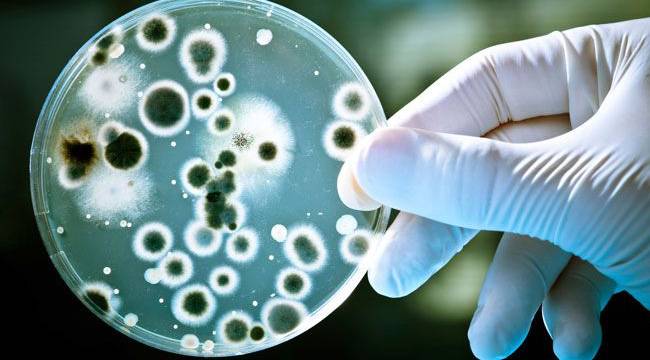

Dünya Sağlık Örgütü acilen yeni antibiyotiklere ihtiyaç olduğu uyarısında bulundu. Uzmanlar ilaçların bakterilerle baş edemeyecek duruma gelmesinin kanserden daha tehlikeli olduğunu söylüyor.Birleşmiş Milletlere bağlı Dünya sağlık Örgütü kuruluşu, antibiyotiklere dirençli 12 öncelikli bakterinin listesini yayımladı. Örgütün İnovasyon Yönetmeni Doktor Marie-Paule Kieny, hükümetleri yeni antibiyotik ve ilaçların bulunmasına katkı sağlamaya çağırdı.Sağlık uzmanları bir süredir yanlış antibiyotik kullanımının, ilaçların vücuda etki etmemesine yol açarak, bakteri enfeksiyonlarının önlenememesi riskini arttırdığına dikkat çekiyor. Uzmanlar ilaçların bakterilerle baş edemeyecek duruma gelmesinin kanserden daha tehlikeli olduğunu söylüyor. İlaca direnç gösteren hastalıklar üzerine uzmanlaşan Wellcome Trust yetkilisi Tim Jinks, antibiyotikler bakterilere etki edemezse organ nakli, sezeryan, kemoterapi ve protez ameliyatları gibi işlemlerin enfeksiyon riski nedeniyle uygulanamayabileceğini söylüyor.BAKTERİLER GRUPLARA AYRILDIDünya Sağlık Örgütü'nün listelediği bakteriler öncelik sırasını belirten 'kritik', 'yüksek' ve 'orta' başlıkları altında üç gruba ayrılıyor. Bu bakterilerin hangi enfeksiyonlara yol açtıkları, ne kadar kolay yayıldıkları, bakterilerle savaşabilen kaç ilaç kaldığı ve bu bakterilerle savaşabilecek yeni ilaçların üstünde çalışılıp çalışılmadığı göz önünde bulunduruluyor.Doktor Kieny, "Bu liste araştırma ve geliştirme bölümlerinin kamu sağlığının acil ihtiyaçlarına yönelmesini sağlayacak" diyor. Örgüt ayrıca 12 bakterinin genetik yapılarının başka bakterileri de ilaçlara dirençli hale getirebildiğini söylüyor. Kritik bakteri grubunda birden fazla ilaca direnç gösterebilen bakteriler bulunuyor. Bu bakteriler kanda oluşan veya zatürre gibi ciddi veya ölümcül enfeksiyolara yol açabiliyor. Yüksek ve orta derecede kritik olan bakterilerse bel soğukluğu salmonelladan kaynaklanan gıda zehirlenmesi gibi daha sık rastlanan hastalıklara yol açabiliyor. Listede tüberküloz yer almıyor çünkü halihazırda tüberküloz için yeni antibiyotikler geliştirmeye çalışan programlar bulunuyor.
Sağlık
Yayınlanma: 03 Mart 2017 - 10:55
DÜNYA SAĞLIK ÖRGÜTÜ UYARDI!
Dünya Sağlık Örgütü antibiyotiklerle ilgili uyarıda bulundu.
Sağlık
03 Mart 2017 - 10:55
İlginizi Çekebilir